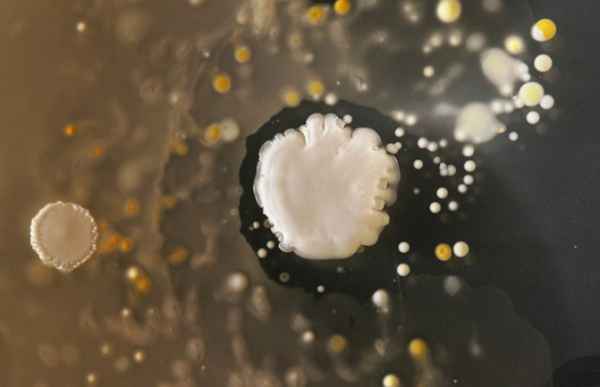
Bactéries

Quand des étudiants cherchent à bien faire leurs devoirs, ils ressortent du laboratoire avec une série de clichés tous plus immondes les uns que les autres. Il faut dire, on leur avait demandé d'étudier les bactéries que l'on retrouve sur les écrans des smartphones. Eh oui, ces choses sont particulièrement sales, puisque vos posez vos mains sales dessus, toute la journée. Comme prévu depuis l'arrivée des smartphones, la zone de prolifération est passée du clavier à la totalité de l'écran.
Plusieurs espèces coabitent sur vos écrans. La plupart sont inoffensives puisqu'elles vivent aussi sur votre peau : ce sont des Microcoques que vous transmettez de votre main à votre smartphone. D'autres, en revanche, sont potentiellement porteuses de maladies, comme les Staphylocoques. Elles constituent plus de 20% de la surface bactériologique de vos appareils. En d'autres termes, il est plus que temps d'investir dans un ensemble de chiffons permettant d'éradiquer tout cela.